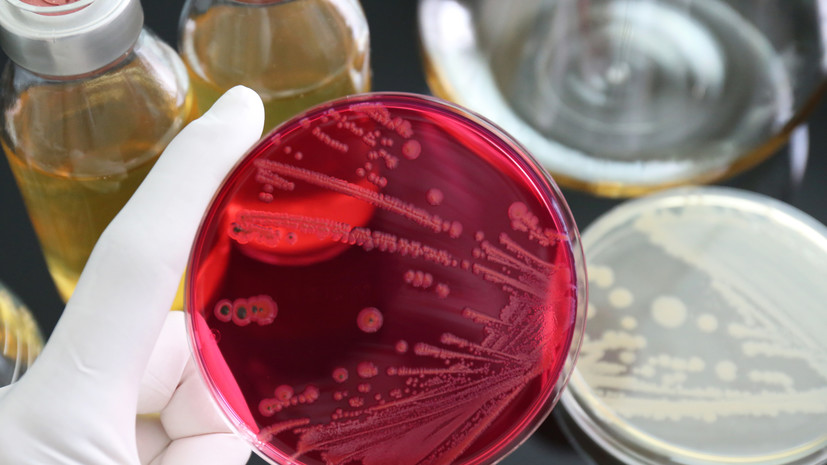
В продукции Кореновского молочно-консервного комбината нашли сальмонеллы

В продукции Кореновского молочно-консервного комбината нашли сальмонеллы
- Gettyimages.ru
Об этом сообщает ТАСС со ссылкой на единый реестр проверок Генеральной прокуратуры России.
«Несоответствие по микробиологическому показателю — патогенные микроорганизмы, в том числе сальмонеллы», — цитирует документ агентство.
При этом конкретный вид молочного продукта с нарушениями не уточняется.
В июле Россельхознадзор обнаружил сальмонеллу в продуктах магазинов торговой сети «Светофор» в Калининградской области.